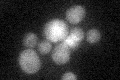
YNL304W
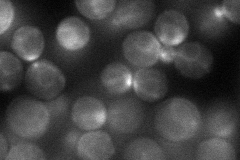
YNL304W
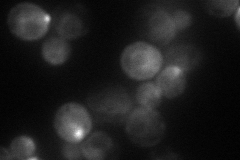
YNL304W
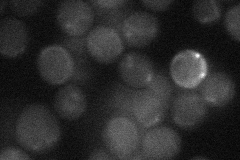
YNL304W
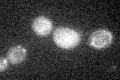
YNL304W

View description
Rab-type small GTPase that interacts with the C-terminal tail domain of Myo2p; mediates distribution of mitochondria and endoplasmic reticuli to daughter cells
Localization:
Intensity:
Fold change:
Significance:
-
C’ GFP library in SD
cytosol18.26 -
N' NOP1pr-GFP in SD
ER,bud56.6586 -
N' TEF2pr-mCherry in SD
ER,bud54.1821 -
N' NATIVEpr-GFP in SD
below threshold20.8211 -
N' TEF2pr-VC and Cyto-VN in SD

bud neck31.9056 -
C’ GFP library in SD+DTT

cytosol15.130.82No -
C’ GFP library in SD+H2O2
cytosol16.860.92No -
C’ GFP library in Starvation Media

cytosol23.131.26No -
C’ GFP library on the background of Pup2-DaMP

cytosol -
C’ GFP library on the background of CCT mutant

cytosol16.71420.914858No
